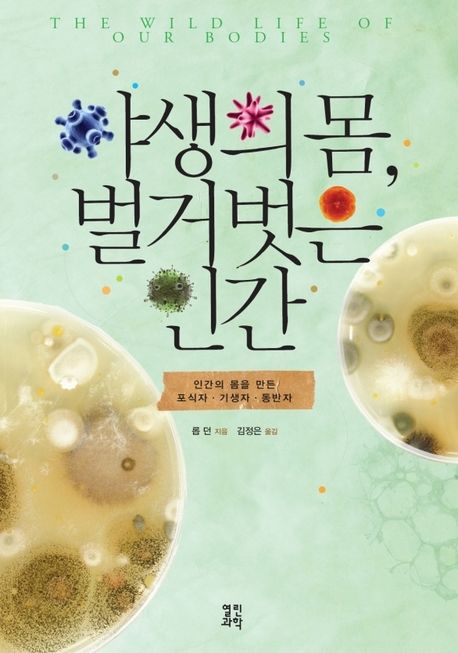

야생의 몸, 벌거벗은 인간 : 우리의 몸을 만든 포식자 기생자 동반자
2012년 12월 20일 출간
국내도서 : 2012년 12월 20일 출간
- eBook 상품 정보
- 파일 정보 ePUB (1.25MB) | 약 19.2만 자
- ISBN 9788992985406
- 지원기기 교보eBook App, PC e서재, 리더기, 웹뷰어
-
교보eBook App
듣기(TTS) 불가능
TTS 란?텍스트를 음성으로 읽어주는 기술입니다.
- 전자책의 편집 상태에 따라 본문의 흐름과 다르게 텍스트를 읽을 수 있습니다.
- 이미지 형태로 제작된 전자책 (예 : ZIP 파일)은 TTS 기능을 지원하지 않습니다.
판매가 판매금지
이 상품은 배송되지 않는 디지털 상품이며,
교보eBook앱이나 웹뷰어에서 바로 이용가능합니다.
카드&결제 혜택
- 5만원 이상 구매 시 추가 2,000P
- 3만원 이상 구매 시, 등급별 2~4% 추가 최대 416P
- 리뷰 작성 시, e교환권 추가 최대 200원
작품소개
이 상품이 속한 분야
저자는 기생충을 시작으로 우리가 직접적으로 의존하는 종들(공생물식물), 포식자, 질병을 차례로 다루고 우리가 서 있는 갈림길을 살펴보고자 한다. 지난 세기 동안 문제를 일으키는 단 한 종의 세균을 제거하기 위해 장 속에 있는 모든 세균을 죽이는 항생제를 사용해온 우리들이 헤아릴 수 없이 많은 생명을 구했지만, 동시에 만성 질환을 증가시키고 자연의 다양성을 감소시켰다고 말하며 더 건강하고 자연에 가까운 삶을 만들기 위해 보다 지혜롭게 행동하기를 바라고 있다.
제 1부 인류의 기원과 생명의 진화
제 2부 우리 몸에 기생충이 필요한 이유
02 건강한 몸이 쇠약해지는 까닭은?
03 위생 가설과 면역계의 기능
04 기생충을 몸속에 집어넣다
제 3부 우리 몸속의 미생물이 하는 일
05 파스퇴르의 의문과 레이니어스의 무균실
06 우리 몸과 미생물의 공생
제 4부 소가 우리를 살찌게 하는 이유
07 소가 인간을 길들이다
08 우유와 유전적 다양성
제 5부 우리는 어떻게 공포와 전율을 느끼게 되었을까?
09 우리는 모두 사냥을 당했다
10 도피에서 공격으로
11 인간의 시각은 뱀에 의해 진화되었다
12 어떤 종을 살릴지 선택하기
제 6부 질병은 어떻게 우리의 행동과 문화에 영향을 미쳤을까?
13 이와 진드기가 우리를 벌거숭이로 만들었을까?
14 외국인 혐오증과 집단주의 문화를 남긴 병원균
제 7부 인간 본성의 미래
15 옥상정원과 수경재배
찾아보기
작가정보

저자 롭 던(Rob Dunn)은 노스캐롤라이나주립대학 생물학과의 교수이다. 대중과학 저술계에서 새롭게 주목을 받고 있는 던은《내셔널 지오그래픽National Geographic》,《내셔널 히스토리National History》,《사이언티픽 아메리칸Scientific American》,《BBC 와일드라이프BBC Wildlife》,《시드Seed》에 80편이 넘는 글을 기고했으며, 최근작으로는《살아있는 모든 것Every Living Thing》이 있다. 그는 아내 모니카와 두 자녀, 그리고 수천 종의 야생동물과 함께 노스캐롤라이나에 살고 있다.
이 상품의 총서
Klover리뷰 (0)
- - e교환권은 적립일로부터 180일 동안 사용 가능합니다.
- - 리워드는 5,000원 이상 eBook, 오디오북, 동영상에 한해 다운로드 완료 후 리뷰 작성 시 익일 제공됩니다. (2024년 9월 30일부터 적용)
- - 리워드는 한 상품에 최초 1회만 제공됩니다.
- - sam 이용권 구매 상품 / 선물받은 eBook은 리워드 대상에서 제외됩니다.
- 도서나 타인에 대해 근거 없이 비방을 하거나 타인의 명예를 훼손할 수 있는 리뷰
- 도서와 무관한 내용의 리뷰
- 인신공격이나 욕설, 비속어, 혐오 발언이 개재된 리뷰
- 의성어나 의태어 등 내용의 의미가 없는 리뷰
구매 후 리뷰 작성 시, e교환권 100원 적립
문장수집
- 구매 후 90일 이내에 문장 수집 등록 시 e교환권 100원을 적립해 드립니다.
- e교환권은 적립일로부터 180일 동안 사용 가능합니다.
- 리워드는 5,000원 이상 eBook에 한해 다운로드 완료 후 문장수집 등록 시 제공됩니다. (2024년 9월 30일부터 적용)
- 리워드는 한 상품에 최초 1회만 제공됩니다.
- sam 이용권 구매 상품 / 선물받은 eBook / 오디오북·동영상 상품/주문취소/환불 시 리워드 대상에서 제외됩니다.
구매 후 문장수집 작성 시, e교환권 100원 적립
신규가입 혜택 지급이 완료 되었습니다.
바로 사용 가능한 교보e캐시 1,000원 (유효기간 7일)
지금 바로 교보eBook의 다양한 콘텐츠를 이용해 보세요!

- 구매 후 90일 이내 작성 시, e교환권 100원 (최초1회)
- 리워드 제외 상품 : 마이 > 라이브러리 > Klover리뷰 > 리워드 안내 참고
- 콘텐츠 다운로드 또는 바로보기 완료 후 리뷰 작성 시 익일 제공
가장 와 닿는 하나의 키워드를 선택해주세요.
총 5MB 이하로 jpg,jpeg,png 파일만 업로드 가능합니다.
신고 사유를 선택해주세요.
신고 내용은 이용약관 및 정책에 의해 처리됩니다.
허위 신고일 경우, 신고자의 서비스 활동이 제한될 수
있으니 유의하시어 신중하게 신고해주세요.
이 글을 작성한 작성자의 모든 글은 블라인드 처리 됩니다.
구매 후 90일 이내 작성 시, e교환권 100원 적립
eBook 문장수집은 웹에서 직접 타이핑 가능하나, 모바일 앱에서 도서를 열람하여 문장을 드래그하시면 직접 타이핑 하실 필요 없이 보다 편하게 남길 수 있습니다.
차감하실 sam이용권을 선택하세요.
차감하실 sam이용권을 선택하세요.
선물하실 sam이용권을 선택하세요.
-
보유 권수 / 선물할 권수0권 / 1권
-
받는사람 이름받는사람 휴대전화
- 구매한 이용권의 대한 잔여권수를 선물할 수 있습니다.
- 열람권은 1인당 1권씩 선물 가능합니다.
- 선물한 열람권이 ‘미등록’ 상태일 경우에만 ‘열람권 선물내역’화면에서 선물취소 가능합니다.
- 선물한 열람권의 등록유효기간은 14일 입니다.
(상대방이 기한내에 등록하지 않을 경우 소멸됩니다.) - 무제한 이용권일 경우 열람권 선물이 불가합니다.
첫 구매 시 교보e캐시 지급해 드립니다.

- 첫 구매 후 3일 이내 다운로드 시 익일 자동 지급
- 한 ID당 최초 1회 지급 / sam 이용권 제외
- 구글바이액션을 통해 교보eBook 구매 이력이 없는 회원 대상
- 교보e캐시 1,000원 지급 (유효기간 지급일로부터 7일)